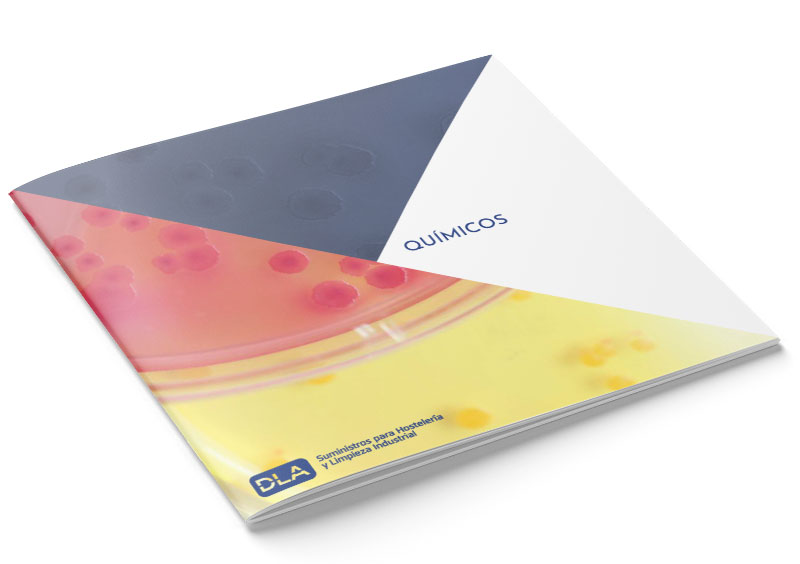

Descarga de Catálogos de Productos
En esta sección de Descarga de Catálogos de Productos DLA se encuentra todos los catálogos de productos de hostelería, productos de limpieza, material para lavandería y catálogo de todo el material necesario para dar sustento a las diferentes empresas enmarcadas dentro del sector de la automoción.
Contacto
Si no encuentras la información que buscas y necesitas una atención más personalizada rellena el siguiente formulario y nos pondremos en contacto contigo.